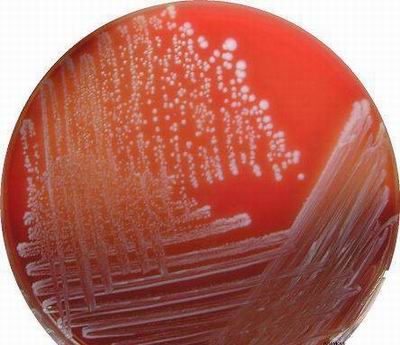
葡萄球菌

葡萄球菌属

微生物实验考试 葡萄球菌
图片尺寸1080x810
aureus ) 是人类的一种重要病原菌,隶属于葡萄球菌属(staphylococcus)
图片尺寸300x300
葡萄球菌
图片尺寸1200x800
葡萄球菌
图片尺寸400x345
葡萄球菌分型
图片尺寸700x591
p>金黄色葡萄球菌(staphylococcus aureus,s.
图片尺寸661x349
葡萄球菌
图片尺寸268x246
葡萄球菌属
图片尺寸502x398
葡萄球菌
图片尺寸939x605
葡萄球菌
图片尺寸352x288
葡萄球菌
图片尺寸634x443
aureus)也称"金葡菌",隶属于葡萄球菌属,是革兰氏阳性菌
图片尺寸472x472
什么是葡萄球菌?
图片尺寸640x480
这个我知道,你是葡萄球菌属的一种,直径约1um,想要看见你必须要借助
图片尺寸1024x1024
表皮葡萄球菌的验证问题
图片尺寸2448x3264
这个我知道,你是葡萄球菌属的一种,直径约1um,想要看见你必须要借助
图片尺寸660x660
葡萄球菌属
图片尺寸566x387
金黄色葡萄球菌也称"金葡菌",隶属于葡萄球菌属,是革兰氏阳性菌代表
图片尺寸1080x776
aureus)也称"金葡菌",隶属于葡萄球菌属,是革兰氏阳性菌代表,为一种
图片尺寸640x469
细菌的基本形态观察 球菌 (葡萄球菌)
图片尺寸1080x810